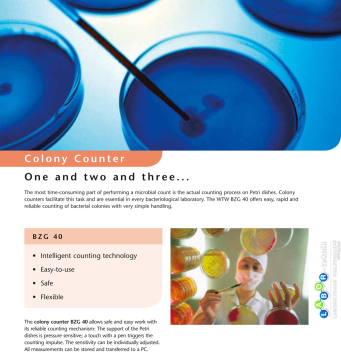
WTW Bzg 40 Koloni Sayıcı (Colony Counter)

0 - Yorum Yap
WTW Bzg 40 Koloni Sayıcı (Colony Counter)
| WTW BZG 40 KOLONİ SAYICI (Colony Counter) |
| WTW BZG 40 Koloni Sayıcı hızlı ve koloyca sayım yaparak bilgisayara aktarmanızı sağlar. |
| Teknik Özellikler |
|
| Işık Kaynağı |
: LED beyaz |
| Ekran | : LED grafik |
| Sayım Çapı |
: 120 mm |
| Arayüz | : RS 232 USB-B |
| Hafıza | : 2 GB SD |
| Ebarlar | : 260 x 330 x 110 mm |
| Ağırlık | : 4.5 kg |
| Genel Özellikler |
| BZG 40 koloni sayım cihazı optik/akustik sayım monitörüne ve farklı Petri kapları için bir otomatik ağırlık dengeleme özelliği |
| Single mod ile tek numune ölçümü, Multi mod'la 20 adet petrinin ölçümü |
| Basınç sensörü sayesinde tüm çalışma yüzeyi üzerinde dengeli bir hassasiyet sağlama |
Bu ürüne ilk yorumu siz yapın!